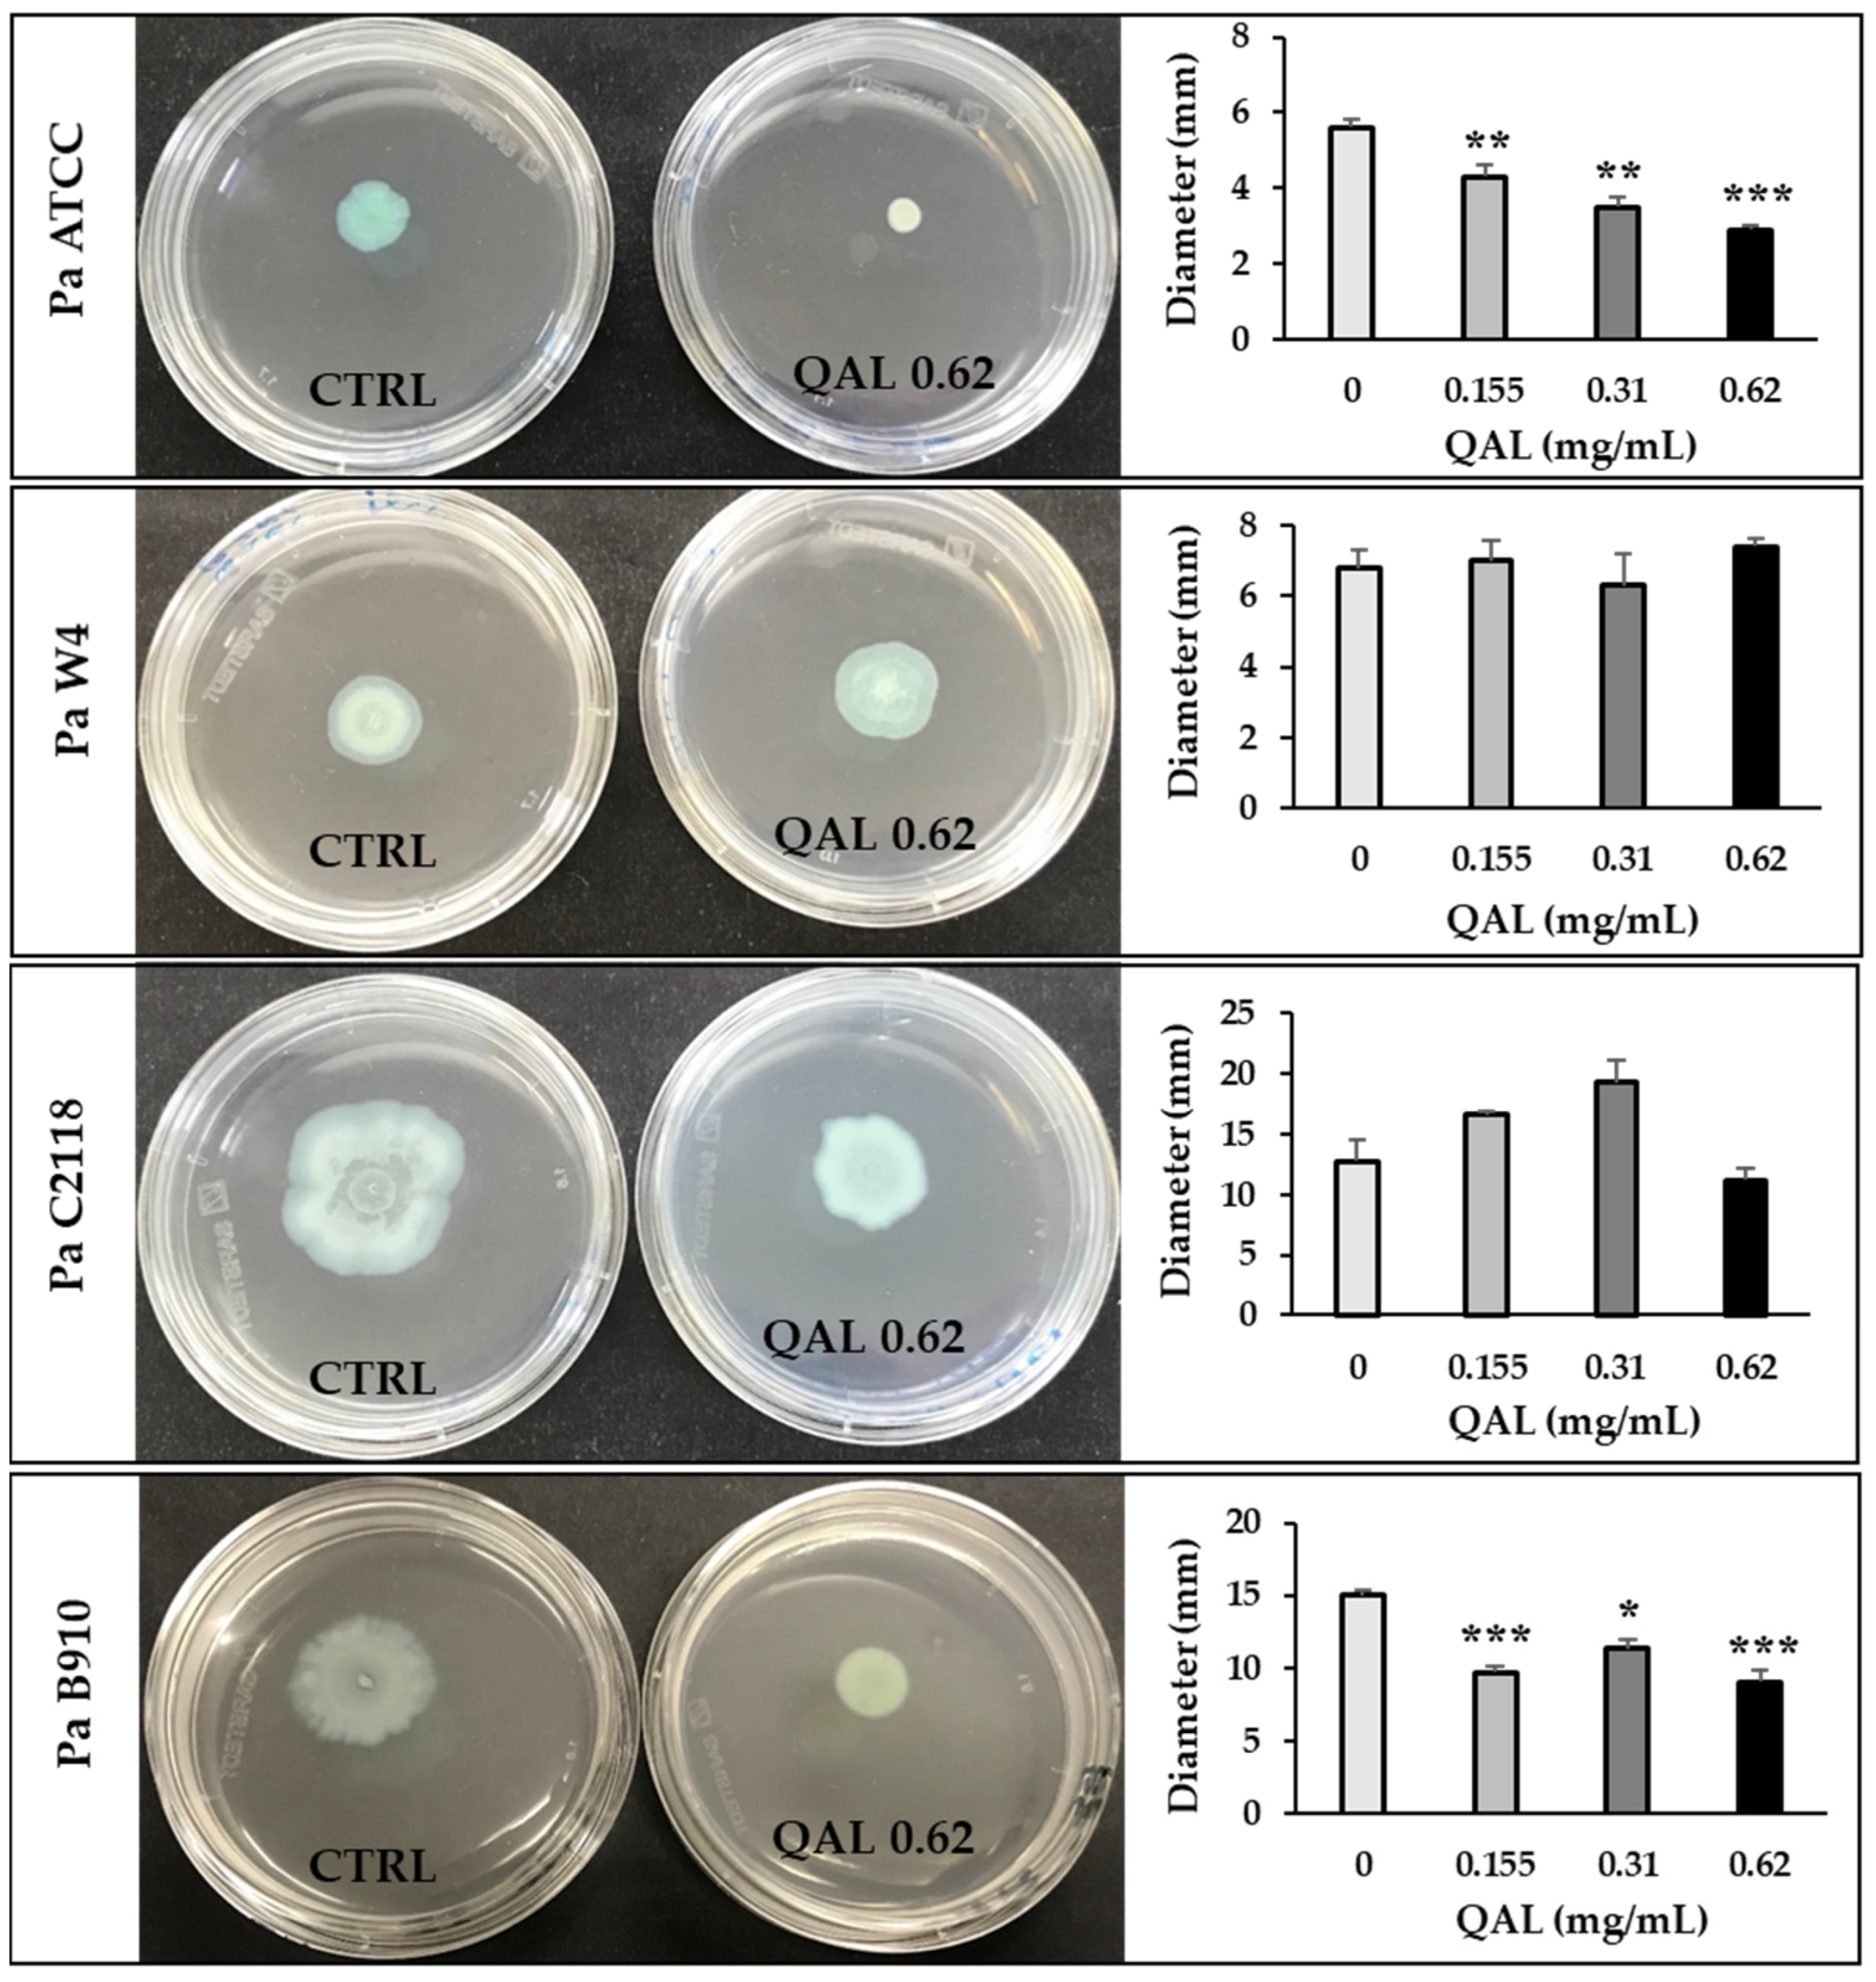
Microorganisms 09 00912 g003 Microorganisms 09 00912 g003

Antivirulence Properties of a Low-Molecular-Weight Quaternized Chitosan Derivative against Pseudomonas aeruginosa
Abstract
1. Introduction
2. Materials and Methods
2.1. Bacterial Strains
2.2. QAL and QAL-Based Nanoparticles
2.3. Determination of Minimal Inhibitory Concentrations (MICs)
2.4. Growth Curves
2.5. Assays for Evaluation of Virulence Factors in Culture Supernatants
2.6. Motility Assay
2.7. Total RNA Isolation and Quantitative Reverse Transcription PCR (qRT-PCR) Analysis
2.8. Flow Cytometry Analysis
2.9. Confocal Scanning Laser Microscopy (CLSM) Analysis
2.10. Biofilm Inhibition Assay
2.11. Planktonic Growth Inhibition Assay
2.12. Statistical Analysis
3. Results
3.1. Determination of MIC Values of QAL against Clinical Isolates of P. aeruginosa
3.2. Effect of Subinhibiting Concentrations of QAL on Growth Curves
3.3. Effects of QAL on Virulence Factor Production
3.4. Inhibition of Swarming Motility by QAL
3.5. Effects of QAL on lasI and rhlI Gene Expression
3.6. Cellular Localization of QAL
3.7. Preparation, Characterization, and Antivirulence Activity of QAL Nanoparticles (QAL-NP)
3.8. Synergistic Effect of QAL in Combination with Tobramycin against P. aeruginosa Strains in Biofilm and Planktonic Modes of Growth
4. Discussion
5. Conclusions
Supplementary Materials
Author Contributions
Funding
Data Availability Statement
Acknowledgments
Conflicts of Interest
References
- Raman, G.; Avendano, E.E.; Chan, J.; Merchant, S.; Puzniak, L. Risk factors for hospitalized patients with resistant or multidrug-resistant Pseudomonas aeruginosa infections: A systematic review and meta-analysis. Antimicrob. Resist. Infect. Control. 2018, 7. [Google Scholar] [CrossRef] [PubMed]
- Rossi, E.; La Rosa, R.; Bartell, J.A.; Marvig, R.L.; Haagensen, J.A.J.; Sommer, L.M.; Molin, S.; Johansen, H.K. Pseudomonas aeruginosa adaptation and evolution in patients with cystic fibrosis. Nat. Rev. Microbiol. 2020. [Google Scholar] [CrossRef]
- Spernovasilis, N.; Psichogiou, M.; Poulakou, G. Skin manifestations of Pseudomonas aeruginosa infections. Curr. Op. Infect. Dis. 2021, 34, 72–79. [Google Scholar] [CrossRef] [PubMed]
- Rello, J.; Kalwaje Eshwara, V.; Lagunes, L.; Alves, J.; Wunderink, R.G.; Conway-Morris, A.; Rojas, J.N.; Alp, E.; Zhang, Z. A global priority list of the TOp TEn resistant microorganisms (TOTEM) study at intensive care: A prioritization exercise based on multi-criteria decision analysis. Eur. J. Clin. Microbiol. Infect. Dis. 2019, 38, 319–323. [Google Scholar] [CrossRef]
- Sauvage, S.; Hardouin, J. Exoproteomics for better understanding Pseudomonas aeruginosa virulence. Toxins 2020, 12, 571. [Google Scholar] [CrossRef] [PubMed]
- Tran Thi, M.T.; Wibowo, D.; Rehm, B.H.A. Pseudomonas aeruginosa biofilms. Int. J. Mol. Sci. 2020, 21, 8671. [Google Scholar] [CrossRef]
- Castillo-Juárez, I.; Maeda, T.; Mandujano-Tinoco, E.A.; Tomás, M.; Pérez-Eretza, B.; García-Contreras, S.J.; Wood, T.K.; García-Contreras, R. Role of quorum sensing in bacterial infections. World J. Clin. Cases 2015, 16, 575–598. [Google Scholar] [CrossRef]
- Hemmati, F.; Salehi, R.; Ghotaslou, R.; Samadi Kafil, H.; Hasani, A.; Gholizadeh, P.; Nouri, R.; Ahangarzadeh Rezaee, M. Quorum Quenching: A potential target for antipseudomonal therapy. Infect. Drug Resist. 2020, 13, 2989–3005. [Google Scholar] [CrossRef]
- Jakobsen, T.H.; Bjarnsholt, T.; Jensen, P.Ø.; Givskov, M.; Høiby, N. Targeting quorum sensing in Pseudomonas aeruginosa biofilms: Current and emerging inhibitors. Future Microbiol. 2013, 8, 901–921. [Google Scholar] [CrossRef]
- Shaaban, M.; Elgaml, A.; Habib, E.E. Biotechnological applications of quorum sensing inhibition as novel therapeutic strategies for multidrug resistant pathogens. Microb. Pathog. 2019, 127, 138–143. [Google Scholar] [CrossRef]
- Baldelli, V.; D’Angelo, F.; Pavoncello, V.; Fiscarelli, E.V.; Visca, P.; Rampioni, G.; Leoni, L. Identification of FDA-approved antivirulence drugs targeting the Pseudomonas aeruginosa quorum sensing effector protein PqsE. Virulence 2020, 11, 652–668. [Google Scholar] [CrossRef]
- Topa, S.H.; Palombo, E.A.; Kingshott, P.; Blackall, L.L. Activity of Cinnamaldehyde on Quorum Sensing and biofilm susceptibility to antibiotics in Pseudomonas aeruginosa. Microorganisms 2020, 8, 455. [Google Scholar] [CrossRef]
- Rubini, D.; Banu, S.F.; Subramani, P.; Hari, B.N.V.; Gowrishankar, S.; Pandian, S.K.; Wilson, A.; Nithyanand, P. Extracted chitosan disrupts quorum sensing mediated virulence factors in urinary tract infection causing pathogens. Pathog. Dis. 2019, 77. [Google Scholar] [CrossRef] [PubMed]
- Muslim, S.N.; Kadmy, I.M.S.A.; Ali, A.N.M.; Salman, B.K.; Ahmad, M.; Khazaal, S.S.; Hussein, N.H.; Muslim, S.N. Chitosan extracted from Aspergillus flavus shows synergistic effect, eases quorum sensing mediated virulence factors and biofilm against nosocomial pathogen Pseudomonas aeruginosa. Int. J. Biol. Macromol. 2018, 107, 52–58. [Google Scholar] [CrossRef] [PubMed]
- Verlee, A.; Mincke, S.; Stevens, C.V. Recent developments in antibacterial and antifungal chitosan and its derivatives. Carbohydr. Polym. 2017, 164, 268–283. [Google Scholar] [CrossRef] [PubMed]
- Fabiano, A.; Beconcini, D.; Migone, C.; Piras, A.M.; Zambito, Y. Quaternary ammonium chitosans: The importance of the positive fixed charge of the drug delivery systems. Int. J. Mol. Sci. 2020, 21, 6617. [Google Scholar] [CrossRef]
- Martins, A.F.; Facchi, S.P.; Follmann, H.D.; Pereira, A.G.; Rubira, A.F.; Muniz, E.C. Antimicrobial activity of chitosan derivatives containing N-quaternized moieties in its backbone: A review. Int. J. Mol. Sci. 2014, 15, 20800–20832. [Google Scholar] [CrossRef]
- Piras, A.M.; Esin, S.; Benedetti, A.; Maisetta, G.; Fabiano, A.; Zambito, Y.; Batoni, G. Antibacterial, antibiofilm, and antiadhesive properties of different quaternized chitosan derivatives. Int. J. Mol. Sci. 2019, 20, 6297. [Google Scholar] [CrossRef]
- Felice, F.; Zambito, Y.; Belardinelli, E.; Fabiano, A.; Santoni, T.; Di Stefano, R. Effect of different chitosan derivatives on in vitro scratch wound assay: A comparative study. Int. J. Biol. Macromol. 2015, 76, 236–241. [Google Scholar] [CrossRef]
- Cesari, A.; Fabiano, A.; Piras, A.M.; Zambito, Y.; Uccello-Barretta, G.; Balzano, F. Binding and mucoadhesion of sulfurated derivatives of quaternary ammonium-chitosans and their nanoaggregates: An NMR investigation. J. Pharm. Biomed. Anal. 2020, 177, 112852–112858. [Google Scholar] [CrossRef]
- Piras, A.M.; Fabiano, A.; Chiellini, F.; Zambito, Y. Methyl-β-cyclodextrin quaternary ammonium chitosan conjugate: Nanoparticles vs. macromolecular soluble complex. Int. J. Nanomed. 2018, 13, 2531–2541. [Google Scholar] [CrossRef]
- Cesari, A.; Recchimurzo, A.; Fabiano, A.; Balzano, F.; Rossi, N.; Migone, C.; Uccello-Barretta, G.; Zambito, Y.; Piras, A.M. Improvement of peptide affinity and stability by complexing to cyclodextrin-grafted ammonium chitosan. Polymers 2020, 12, 474. [Google Scholar] [CrossRef]
- Fabiano, A.; Piras, A.M.; Guazzelli, L.; Storti, B.; Bizzarri, R.; Zambito, Y. Impact of different mucoadhesive polymeric nanoparticles loaded in thermosensitive hydrogels on transcorneal administration of 5-Fluorouracil. Pharmaceutics 2019, 11, 623. [Google Scholar] [CrossRef]
- Migone, C.; Mattii, L.; Giannasi, M.; Moscato, S.; Cesari, A.; Zambito, Y.; Piras, A.M. Nanoparticles based on quaternary ammonium chitosan-methyl-β-cyclodextrin conjugate for the neuropeptide dalargin delivery to the central nervous system: An in vitro study. Pharmaceutics 2020, 13, 5. [Google Scholar] [CrossRef] [PubMed]
- Zambito, Y.; Uccello-Barretta, G.; Zaino, C.; Balzano, F.; Di Colo, G. Novel transmucosal absorption enhancers obtained by aminoalkylation of chitosan. Eur. J. Pharm. Sci. 2006, 29, 460–469. [Google Scholar] [CrossRef] [PubMed]
- Essar, D.W.; Eberly, L.; Hadero, A.; Crawford, I.P. Identification and characterization of genes for a second anthranilate synthase in Pseudomonas aeruginosa: Interchangeability of the two anthranilate synthases and evolutionary implications. J. Bacteriol. 1990, 172, 884–900. [Google Scholar] [CrossRef] [PubMed]
- El-Mowafy, S.A.; Abd El Galil, K.H.; El-Messery, S.M.; Shaaban, M.I. Aspirin is an efficient inhibitor of quorum sensing, virulence and toxins in Pseudomonas aeruginosa. Microb. Pathogen. 2014, 74, 25–32. [Google Scholar] [CrossRef]
- Kessler, E.; Safrin, M.; Olson, J.C.; Ohman, D.E. Secreted LasA of Pseudomonas aeruginosa is a staphylolytic protease. J. Biol. Chem. 1993, 268, 7503–7508. [Google Scholar] [CrossRef]
- Schmittgen, T.D.; Livak, K.J. Analyzing real-time PCR data by the comparative C(T) method. Nat. Protoc. 2008, 3, 1101–1108. [Google Scholar] [CrossRef]
- Badawy, M.; Riad, O.; Taher, F.A.; Zaki, S.A. Chitosan and chitosan-zinc oxide nanocomposite inhibit expression of LasI and RhlI genes and quorum sensing dependent virulence factors of Pseudomonas aeruginosa. Int. J. Biol. Macromol. 2020, 149, 1109–1117. [Google Scholar] [CrossRef]
- Maisetta, G.; Batoni, G.; Caboni, P.; Esin, S.; Rinaldi, A.C.; Zucca, P. Tannin profile, antioxidant properties, and antimicrobial activity of extracts from two Mediterranean species of parasitic plant Cytinus. BMC Complement. Altern. Med. 2019, 19, 82. [Google Scholar] [CrossRef]
- Rada, B.; Leto, T.L. Pyocyanin effects on respiratory epithelium: Relevance in Pseudomonas aeruginosa airway infections. Trends Microbiol. 2013, 21, 73–81. [Google Scholar] [CrossRef]
- Edgar, R.J.; Hampton, G.E.; Garcia, G.; Maher, M.J.; Perugini, M.A.; Ackerley, D.F.; Lamont, I.L. Integrated activities of two alternative sigma factors coordinate iron acquisition and uptake by Pseudomonas aeruginosa. Mol. Microb. 2017, 106, 891–904. [Google Scholar] [CrossRef]
- Suleman, L. Extracellular bacterial proteases in chronic wounds: A potential therapeutic target? Adv. Wound Care 2016, 5, 455–463. [Google Scholar] [CrossRef]
- D’Orazio, M.; Mastropasqua, M.C.; Cerasi, M.; Pacello, F.; Consalvo, A.; Chirullo, B.; Mortensen, B.; Skaar, E.P.; Ciavardelli, D.; Pasquali, P.; et al. The capability of Pseudomonas aeruginosa to recruit zinc under conditions of limited metal availability is affected by inactivation of the ZnuABC transporter. Metallomics 2015, 7, 1023–1035. [Google Scholar] [CrossRef] [PubMed]
- Pletzer, D.; Sun, E.; Ritchie, C.; Wilkinson, L.; Liu, L.T.; Trimble, M.J.; Wolfmeier, H.; Blimkie, T.M.; Hancock, R. Surfing motility is a complex adaptation dependent on the stringent stress response in Pseudomonas aeruginosa LESB58. PLoS Pathog. 2020, 16, e1008444. [Google Scholar] [CrossRef] [PubMed]
- Lee, C.; Klockgether, J.; Fischer, S.; Trcek, J.; Tümmler, B.; Römling, U. Why?—Successful Pseudomonas aeruginosa clones with a focus on clone C. FEMS Microbiol. Rev. 2020, 44, 740–762. [Google Scholar] [CrossRef]
- Moradali, M.F.; Ghods, S.; Rehm, B.H. Pseudomonas aeruginosa Lifestyle: A paradigm for adaptation, survival, and persistence. Front. Cell. Infect. Microbiol. 2017, 7, 39. [Google Scholar] [CrossRef] [PubMed]
- Cornelis, P.; Dingemans, J. Pseudomonas aeruginosa adapts its iron uptake strategies in function of the type of infections. Front. Cell. Infect. Microbiol. 2013, 3, 75. [Google Scholar] [CrossRef]
- Meyer, J.M.; Neely, A.; Stintzi, A.; Georges, C.; Holder, I.A. Pyoverdin is essential for virulence of Pseudomonas aeruginosa. Infect. Immun. 1996, 64, 518–523. [Google Scholar] [CrossRef]
- Kang, D.; Revtovich, A.V.; Chen, Q.; Shah, K.N.; Cannon, C.L.; Kirienko, N.V. Pyoverdine-dependent virulence of Pseudomonas aeruginosa isolates from cystic fibrosis patients. Front. Microbiol. 2019, 10, 2048. [Google Scholar] [CrossRef]
- von Ambüren, J.; Schreiber, F.; Fischer, J.; Winter, S.; van Gumpel, E.; Simonis, A.; Rybniker, J. Comprehensive host cell-based screening assays for identification of anti-virulence drugs targeting Pseudomonas aeruginosa and Salmonella Typhimurium. Microorganisms 2020, 8, 1096. [Google Scholar] [CrossRef]
- Kumar, M.N.; Muzzarelli, R.A.; Muzzarelli, C.; Sashiwa, H.; Domb, A.J. Chitosan chemistry and pharmaceutical perspectives. Chem. Rev. 2004, 104, 6017–6084. [Google Scholar] [CrossRef]
- Kenawy, E.R.; Abdel-Hay, F.I.; El-Raheem, A.; El-Shanshoury, R.; El-Newehy, M.H. Biologically active polymers: Synthesis and antimicrobial activity of modified glycidyl methacrylate polymers having a quaternary ammonium and phosphonium groups. J. Control. Release 1998, 50, 145–152. [Google Scholar] [CrossRef]
- Chi, W.; Qin, C.; Zeng, L.; Li, W.; Wang, W. Microbiocidal activity of chitosan-N-2-hydroxypropyl trimethyl ammonium chloride. J. Appl. Polym. Sci. 2007, 103, 3851–3856. [Google Scholar] [CrossRef]
- Dietrich, L.E.; Price-Whelan, A.; Petersen, A.; Whiteley, M.; Newman, D.K. The phenazine pyocyanin is a terminal signalling factor in the quorum sensing network of Pseudomonas aeruginosa. Mol. Microbiol. 2006, 61, 1308–1321. [Google Scholar] [CrossRef] [PubMed]
- Maisetta, G.; Grassi, L.; Esin, S.; Kaya, E.; Morelli, A.; Puppi, D.; Piras, M.; Chiellini, F.; Pifferi, M.; Batoni, G. Targeting Pseudomonas aeruginosa in the Sputum of Primary Ciliary Dyskinesia Patients with a Combinatorial Strategy Having Antibacterial and Anti-Virulence Potential. Int. J. Mol. Sci. 2019, 21, 69. [Google Scholar] [CrossRef] [PubMed]
- Guendouze, A.; Plener, L.; Bzdrenga, J.; Jacquet, P.; Rémy, B.; Elias, M.; Lavigne, J.P.; Daudé, D.; Chabrière, E. Effect of Quorum Quenching Lactonase in Clinical Isolates of Pseudomonas aeruginosa and Comparison with Quorum Sensing Inhibitors. Front. Microbiol. 2017, 8, 227. [Google Scholar] [CrossRef] [PubMed]
- Muller, M.; Li, Z.; Maitz, P.K. Pseudomonas pyocyanin inhibits wound repair by inducing premature cellular senescence: Role for p38 mitogen-activated protein kinase. Burns 2009, 35, 500–508. [Google Scholar] [CrossRef] [PubMed]
- Lee, J.; Zhang, L. The hierarchy quorum sensing network in Pseudomonas aeruginosa. Protein Cell 2015, 6, 26–41. [Google Scholar] [CrossRef]
- Coleman, S.R.; Pletzer, D.; Hancock, R. Contribution of swarming motility to dissemination in a Pseudomonas aeruginosa murine skin abscess infection model. J. Infect. Dis. 2020. [Google Scholar] [CrossRef] [PubMed]
- Schmidt, J.; Müsken, M.; Becker, T.; Magnowska, Z.; Bertinetti, D.; Möller, S.; Zimmermann, B.; Herberg, F.W.; Jänsch, L.; Häussler, S. The Pseudomonas aeruginosa chemotaxis methyltransferase CheR1 impacts on bacterial surface sampling. PLoS ONE 2011, 6, e18184. [Google Scholar] [CrossRef] [PubMed]
- García-Contreras, R.; Peréz-Eretza, B.; Jasso-Chávez, R.; Lira-Silva, E.; Roldán-Sánchez, J.A.; González-Valdez, A.; Soberón-Chávez, G.; Coria-Jiménez, R.; Martínez-Vázquez, M.; Alcaraz, L.D.; et al. High variability in quorum quenching and growth inhibition by furanone C-30 in Pseudomonas aeruginosa clinical isolates from cystic fibrosis patients. Pathog. Dis. 2015, 73. [Google Scholar] [CrossRef]
- García-Lara, B.; Saucedo-Mora, M.Á.; Roldán-Sánchez, J.A.; Pérez-Eretza, B.; Ramasamy, M.; Lee, J.; Coria-Jimenez, R.; Tapia, M.; Varela-Guerrero, V.; García-Contreras, R. Inhibition of quorum-sensing-dependent virulence factors and biofilm formation of clinical and environmental Pseudomonas aeruginosa strains by ZnO nanoparticles. Lett. Appl. Microbiol. 2015, 61, 299–305. [Google Scholar] [CrossRef]
- Uzunbayir-Akel, N.; Tekintas, Y.; Yilmaz, F.F.; Ozturk, I.; Okeer, M.; Aydemir, S.S.; Cilli, F.F.; Hosgor-Limoncu, M. Effects of disinfectants and ciprofloxacin on quorum sensing genes and biofilm of clinical Pseudomonas aeruginosa isolates. J. Infect. Public Health 2020, 13, 1932–1938. [Google Scholar] [CrossRef]
- Bano, I.; Ghauri, M.A.; Arshad, M.; Yasin, T.; Younus, M. Bioactivity of variant molecular weight chitosan against drug-resistant bacteria isolated from human wounds. Microb. Drug Resist. 2017, 23, 958–965. [Google Scholar] [CrossRef]
- Williams, P.; Cámara, M. Quorum sensing and environmental adaptation in Pseudomonas aeruginosa: A tale of regulatory networks and multifunctional signal molecules. Curr. Opin. Microbiol. 2009, 12, 182–191. [Google Scholar] [CrossRef]
- Jimenez, P.N.; Koch, G.; Thompson, J.A.; Xavier, K.B.; Cool, R.H.; Quax, W.J. The multiple signaling systems regulating virulence in Pseudomonas aeruginosa. Microbiol. Mol. Biol. Rev. 2012, 76, 46–65. [Google Scholar] [CrossRef]
- Kostylev, M.; Kim, D.Y.; Smalley, N.E.; Salukhe, I.; Greenberg, E.P.; Dandekar, A.A. Evolution of the Pseudomonas aeruginosa quorum-sensing hierarchy. Proc. Natl. Acad. Sci. USA 2019, 116, 7027–7032. [Google Scholar] [CrossRef]
- Lesprit, P.; Faurisson, F.; Join-Lambert, O.; Roudot-Thoraval, F.; Foglino, M.; Vissuzaine, C.; Carbon, C. Role of the quorum-sensing system in experimental pneumonia due to Pseudomonas aeruginosa in rats. Am. J. Respir. Crit. Care Med. 2003, 167, 1478–1482. [Google Scholar] [CrossRef] [PubMed]
- Wu, H.; Song, Z.; Givskov, M.; Doring, G.; Worlitzsch, D.; Mathee, K.; Rygaard, J.; Høiby, N. Pseudomonas aeruginosa mutations in lasI and rhlI quorum sensing systems result in milder chronic lung infection. Microbiology 2001, 147, 1105–1113. [Google Scholar] [CrossRef]
- Rumbaugh, K.P.; Griswold, J.A.; Iglewski, B.H.; Hamood, A.N. Contribution of quorum sensing to the virulence of Pseudomonas aeruginosa in burn wound infections. Infect. Immun. 1999, 67, 5854–5862. [Google Scholar] [CrossRef]
- Jurado-Martín, I.; Sainz-Mejías, M.; McClean, S. Pseudomonas aeruginosa: An Audacious Pathogen with an Adaptable Arsenal of Virulence Factors. Int. J. Mol. Sci. 2021, 22, 3128. [Google Scholar] [CrossRef]
- Riaz Rajoka, M.S.; Mehwish, H.M.; Wu, Y.; Zhao, L.; Arfat, Y.; Majeed, K.; Anwaar, S. Chitin/chitosan derivatives and their interactions with microorganisms: A comprehensive review and future perspectives. Crit. Rev. Biotechnol. 2020, 40, 365–379. [Google Scholar] [CrossRef]
- Raafat, D.; Sahl, H.G. Chitosan and its antimicrobial potential—A critical literature survey. Microb. Biotechnol. 2009, 2, 186–201. [Google Scholar] [CrossRef] [PubMed]
- Liu, X.F.; Guan, Y.L.; Yang, D.Z.; Li, Z.; Yao, K.D. Antibacterial action of chitosan and carboxymethylated Chitosan. J. Appl. Polym. Sci. 2001, 79, 1324–1335. [Google Scholar]
- Malekshah, R.E.; Shakeri, F.; Aallaei, M.; Hemati, M.; Khaleghian, A. Biological evaluation, proposed molecular mechanism through docking and molecular dynamic simulation of derivatives of chitosan. Int. J. Biol. Macromol. 2021, 166, 948–966. [Google Scholar] [CrossRef]
- Xing, K.; Chen, X.G.; Liu, C.S.; Cha, D.S.; Park, H.J. Oleoyl-chitosan nanoparticles inhibits Escherichia coli and Staphylococcus aureus by damaging the cell membrane and putative binding to extracellular or intracellular targets. Int. J. Food Microbiol. 2009, 132, 127–133. [Google Scholar] [CrossRef] [PubMed]
- Garland, M.; Loscher, S.; Bogyo, M. Chemical strategies to target bacterial virulence. Chem. Rev. 2017, 117, 4422–4461. [Google Scholar] [CrossRef]
- Rezzoagli, C.; Archetti, M.; Mignot, I.; Baumgartner, M.; Kümmerli, R. Combining antibiotics with antivirulence compounds can have synergistic effects and reverse selection for antibiotic resistance in Pseudomonas aeruginosa. PLoS Biol. 2020, 18, e3000805. [Google Scholar] [CrossRef]
- Shang, D.; Han, X.; Du, W.; Kou, Z.; Jiang, F. Trp-containing antibacterial peptides impair quorum sensing and biofilm development in multidrug-resistant Pseudomonas aeruginosa and exhibit synergistic effects with antibiotics. Front. Microbiol. 2021, 12. [Google Scholar] [CrossRef]
- Vipin, C.; Saptami, K.; Fida, F.; Mujeeburahiman, M.; Rao, S.S.; Athmika; Arun, A.B.; Rekha, P.D. Potential synergistic activity of quercetin with antibiotics against multidrug-resistant clinical strains of Pseudomonas aeruginosa. PLoS ONE 2020, 15, e0241304. [Google Scholar] [CrossRef] [PubMed]
- Conway, S.P. Nebulized antibiotic therapy: The evidence. Chron. Respir. Dis. 2005, 2, 35–41. [Google Scholar] [CrossRef] [PubMed]
- Taccetti, G.; Francalanci, M.; Pizzamiglio, G.; Messore, B.; Carnovale, V.; Cimino, G.; Cipolli, M. Cystic fibrosis: Recent insights into inhaled antibiotic treatment and future perspectives. Antibiotics 2021, 10, 338. [Google Scholar] [CrossRef] [PubMed]
- Brogden, R.N.; Pinder, R.M.; Sawyer, P.R.; Speight, T.M.; Avery, G.S. Tobramycin: A review of its antibacterial and pharmacokinetic properties and therapeutic use. Drugs 1976, 12, 166–200. [Google Scholar] [CrossRef]

| Strain | Abbreviation | Isolation Site | Resistance Profile | MIC (mg/mL) |
|---|---|---|---|---|
| P. aeruginosa ATCC 27853 | Pa ATCC | Blood | none | 5 |
| P. aeruginosa W4 | PaW4 | Diabetic wound | none | 5 |
| P. aeruginosa CVC02118 | Pa C2118 | Central venous catheter | CAZ, PIP, TZP | 2.5 |
| P. aeruginosa BAL0910 | Pa B910 | BAL | CIP, LVX | 5 |
Publisher’s Note: MDPI stays neutral with regard to jurisdictional claims in published maps and institutional affiliations. |
© 2021 by the authors. Licensee MDPI, Basel, Switzerland. This article is an open access article distributed under the terms and conditions of the Creative Commons Attribution (CC BY) license (https://creativecommons.org/licenses/by/4.0/).
Share and Cite
Maisetta, G.; Piras, A.M.; Motta, V.; Braccini, S.; Mazzantini, D.; Chiellini, F.; Zambito, Y.; Esin, S.; Batoni, G. Antivirulence Properties of a Low-Molecular-Weight Quaternized Chitosan Derivative against Pseudomonas aeruginosa. Microorganisms 2021, 9, 912. https://doi.org/10.3390/microorganisms9050912
Maisetta G, Piras AM, Motta V, Braccini S, Mazzantini D, Chiellini F, Zambito Y, Esin S, Batoni G. Antivirulence Properties of a Low-Molecular-Weight Quaternized Chitosan Derivative against Pseudomonas aeruginosa. Microorganisms. 2021; 9(5):912. https://doi.org/10.3390/microorganisms9050912
Chicago/Turabian StyleMaisetta, Giuseppantonio, Anna Maria Piras, Vincenzo Motta, Simona Braccini, Diletta Mazzantini, Federica Chiellini, Ylenia Zambito, Semih Esin, and Giovanna Batoni. 2021. "Antivirulence Properties of a Low-Molecular-Weight Quaternized Chitosan Derivative against Pseudomonas aeruginosa" Microorganisms 9, no. 5: 912. https://doi.org/10.3390/microorganisms9050912
APA StyleMaisetta, G., Piras, A. M., Motta, V., Braccini, S., Mazzantini, D., Chiellini, F., Zambito, Y., Esin, S., & Batoni, G. (2021). Antivirulence Properties of a Low-Molecular-Weight Quaternized Chitosan Derivative against Pseudomonas aeruginosa. Microorganisms, 9(5), 912. https://doi.org/10.3390/microorganisms9050912

